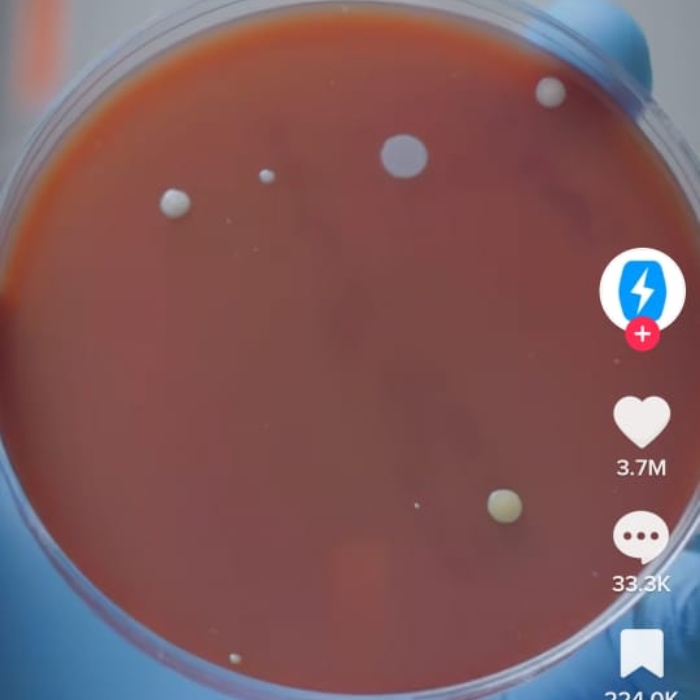

Lelaki Buat Eksperimen, Ini Hasil Bakteria & Kulat Selepas Guna Pengering Tangan Dalam Tandas
Secara lazimnya, manusia akan membasuh tangan selepas memasuki tandas. Ini disebabkan tempat tersebut merupakan antara tempat yang paling banyak mengandungi kuman-kuman yang boleh menyebabkan kita jatuh sakit.
Antara lokasi-lokasi yang menjadi kawasan tumpuan bagi kuman-kuman ini untuk membiak seperti pelapik duduk mangkuk tandas, penarik pam, kepala paip, tombol pintu, sinki dan sebagainya.
Biasanya, selepas membasuh tangan kita cenderung untuk menggunakan pengering tangan yang disediakan untuk mengeringkan tangan. Namun, apakah status udara panas yang dikeluarkan oleh pengering tersebut? Adakah udaranya benar-benar bersih dan sihat?
Justeru, sebuah akaun TikTok, Phone Soap yang sering menjalankan eksperimen berkenaan bakteria dan kulat yang ada pada peralatan harian yang sering digunakan turut melakukan eksperimen ke atas mesin pengering tangan ini.
Dalam eksperimen ini, mereka melakukan eksperimen terhadap dua jenis tempat pengering tangan secara rawak. Hasilnya, mendapati mesin pengering tangan pertama lebih banyak menghasilkan koloni kuman pada jeli kultur berbanding mesin pengering tangan yang kedua.
@phonesoap How sanitary are air hand dryers? #phonesoap #bacteria #whatisdirtier
Disebabkan penemuan yang agak mengejutkan ini, pihak Phone Soap sekali lagi mengadakan eksperimen tersebut dengan mengubah pembolehubah seperti menguji tahap kebersihan mesin pengering tangan di beberapa lokasi berbeza.
Bagi piring petri yang pertama, pihak Phone Soap tidak mengenakan mesin pengering tangan pada jeli kultur mereka.
Sebaliknya, mereka sekadar mengibaskan piring petri tersebut untuk meniru perbuatan manusia yang sekadar mengibaskan tangan mereka selepas membasuh tangan.
Seterusnya, piring petri kedua, ketiga, keempat dan kelma telah dikenakan pada mesin pengering tangan di lokasi berbeza seperti lokasi asal eksperimen, stesen minyak, panggung wayang dan pasar raya.
Semua piring petri yang mengandungi jeli kultur akan diletakkan dalam mesin inkubator selama tiga hari.
Selepas tiga hari, keputusannya sangat mengejutkan.
Tiga hari sudah berlalu, maka perubahan yang terdapat pada jeli kultur dapat dilihat menerusi mata kasar. Piring petri yang pertema menunjukkan keputusan yang mengejutkan apabila kehadiran bakteria yang ketara pada jeli kultur.

Bagi piring petri kedua, ia menunjukkan keputusan yang serupa dengan sebelum ini iaitu, pertumbuhan ketara sehingga memenuhi keseluruhan jeli kultur.

Manakala, permukaan jeli kultur pada piring petri ketiga, keempat dan kelima adalah berbeza-beza mengikut lokasi mesin pengering tangan.
Permukaan jeli kultur yang dikenakan pada mesin pengering tangan di stesen minyak mengahasilkan koloni kuman yang lebih kurang sama dengan hasil piring petri kedua.

Dalam pada itu, mesin pengering tangan di panggung wayang menghasilkan koloni kuman yang lebih kecil berbanding kedua-dua piring petri sebelum ini dan mesin pengering tangan di pasar raya mengahsilkan koloni kuman paling kecil, iaitu hanya beberapa tompokan sahaja.

Walaupun hasil piring petri di pasar raya menunjukkan pertumbuhan kuman yang kurang signifikan, ia masih tidak dapat menandingi keputusan piring petri pertama iaitu, dengan hanya mengibaskan tangan.
Pada akhir video tersebut, pihak Phone Soap menasihati orang ramai untuk hanya mengibaskan tangan sahaja, tanpa menggunakan mesin pengering tangan selepas membasuh kedua-dua tangan anda di tandas.
@phonesoap How germy are hand air dryers…again?#PrimeDayDreamDeals #phonesoap
Anda pula ‘team‘ yang mana satu? Guna mesin pengering tangan, mengelap tangan dengan tisu atau geng kibaskan tangan?
BACA: Hanya ‘Secebis’ Milimeter, Gol Kontroversi Jepun ‘Tendang’ Keluar Jerman Dari Piala Dunia


